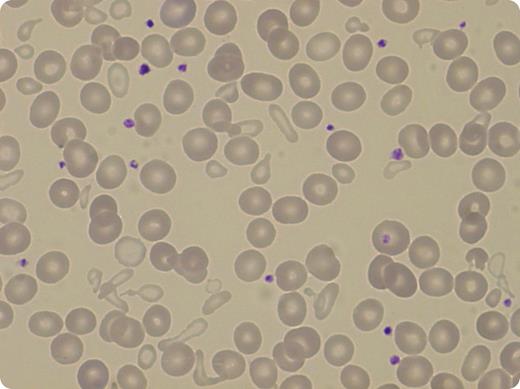
A 42-year-old woman was referred to hematology for a mild chronic nonregenerative microcytic anemia discovered 18 years before. The physical examination was normal. The hemoglobin level was 9.6 g/dL, with a mean corpuscular volume at 73 fL and mean hemoglobin content at 23 pg; the red cell distribution width value was high (27%). The leukocyte and platelet counts were normal. The plasma ferritin level was increased (465 µg/L). Magnetic resonance imaging confirmed significant iron overload in the liver, estimated at 340 µmol/g. No common mutation of the HFE gene was found, excluding iron liver overload attributable to a genetic primary hemochromatosis. Smear examination showed striking poikilocytosis with presence of a double population of erythrocytes, one normal and the other extremely microcytic and hypochromic. In the bone marrow aspirate, 35% of erythroid cells were ring sideroblasts. / DNA sequencing of the ALAS2 gene confirmed the diagnosis of X-linked sideroblastic anemia, detecting the heterozygous mutation c.787G>A (Asp263Asn). The HUMARA assay of blood leukocytes revealed a skewed X-chromosome inactivation ratio of 90:10, explaining the hematologic phenotype. Oral pyridoxine therapy increased the level of hemoglobin up to 11.4 g/dL, and peripheral blood smears showed disappearance of the microcytic population.

A 42-year-old woman was referred to hematology for a mild chronic nonregenerative microcytic anemia discovered 18 years before. The physical examination was normal. The hemoglobin level was 9.6 g/dL, with a mean corpuscular volume at 73 fL and mean hemoglobin content at 23 pg; the red cell distribution width value was high (27%). The leukocyte and platelet counts were normal. The plasma ferritin level was increased (465 µg/L). Magnetic resonance imaging confirmed significant iron overload in the liver, estimated at 340 µmol/g. No common mutation of the HFE gene was found, excluding iron liver overload attributable to a genetic primary hemochromatosis. Smear examination showed striking poikilocytosis with presence of a double population of erythrocytes, one normal and the other extremely microcytic and hypochromic. In the bone marrow aspirate, 35% of erythroid cells were ring sideroblasts.
DNA sequencing of the ALAS2 gene confirmed the diagnosis of X-linked sideroblastic anemia, detecting the heterozygous mutation c.787G>A (Asp263Asn). The HUMARA assay of blood leukocytes revealed a skewed X-chromosome inactivation ratio of 90:10, explaining the hematologic phenotype. Oral pyridoxine therapy increased the level of hemoglobin up to 11.4 g/dL, and peripheral blood smears showed disappearance of the microcytic population.
A 42-year-old woman was referred to hematology for a mild chronic nonregenerative microcytic anemia discovered 18 years before. The physical examination was normal. The hemoglobin level was 9.6 g/dL, with a mean corpuscular volume at 73 fL and mean hemoglobin content at 23 pg; the red cell distribution width value was high (27%). The leukocyte and platelet counts were normal. The plasma ferritin level was increased (465 µg/L). Magnetic resonance imaging confirmed significant iron overload in the liver, estimated at 340 µmol/g. No common mutation of the HFE gene was found, excluding iron liver overload attributable to a genetic primary hemochromatosis. Smear examination showed striking poikilocytosis with presence of a double population of erythrocytes, one normal and the other extremely microcytic and hypochromic. In the bone marrow aspirate, 35% of erythroid cells were ring sideroblasts.
DNA sequencing of the ALAS2 gene confirmed the diagnosis of X-linked sideroblastic anemia, detecting the heterozygous mutation c.787G>A (Asp263Asn). The HUMARA assay of blood leukocytes revealed a skewed X-chromosome inactivation ratio of 90:10, explaining the hematologic phenotype. Oral pyridoxine therapy increased the level of hemoglobin up to 11.4 g/dL, and peripheral blood smears showed disappearance of the microcytic population.
For additional images, visit the ASH IMAGE BANK, a reference and teaching tool that is continually updated with new atlas and case study images. For more information visit http://imagebank.hematology.org.